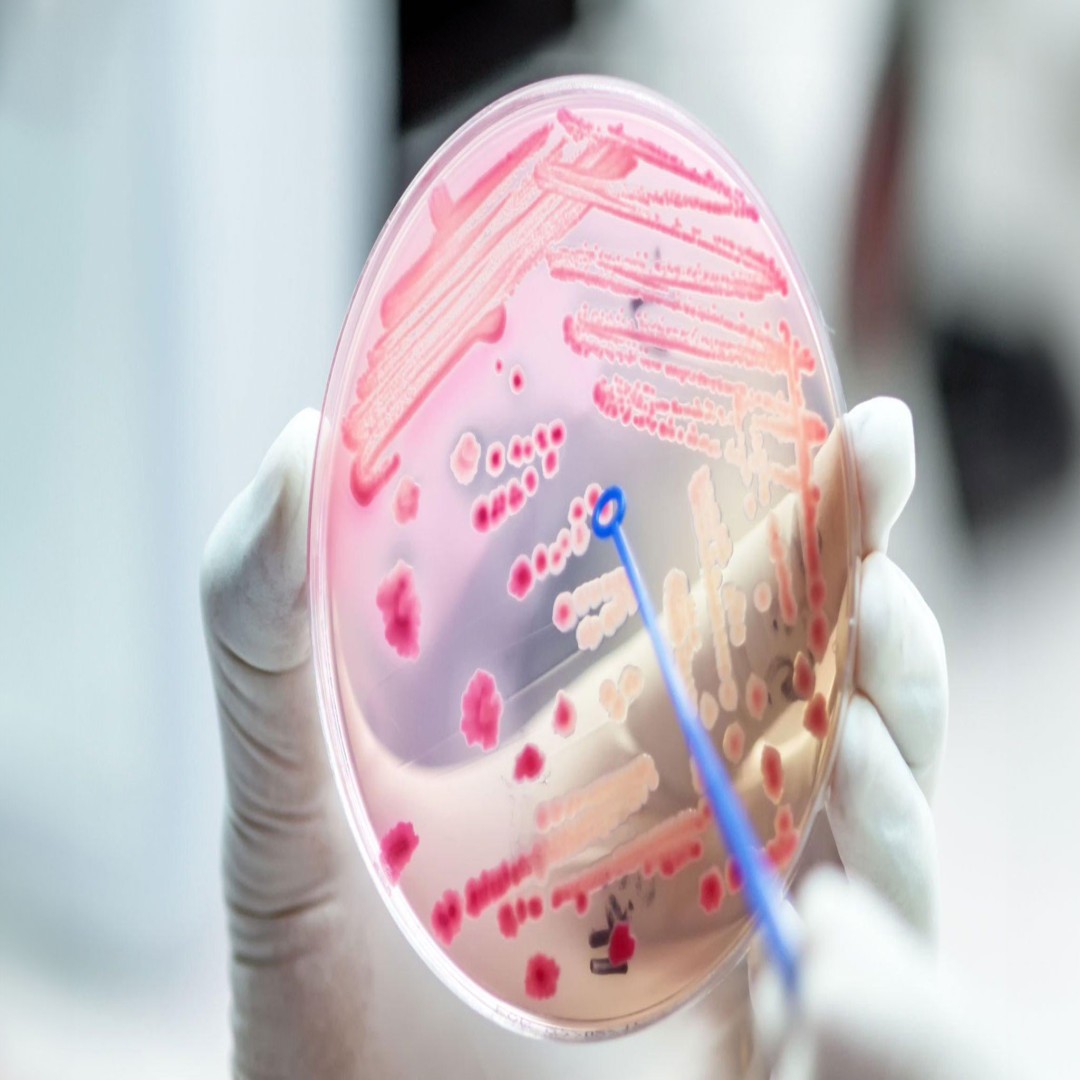
Sepsis Tanısı: Kan Dolaşımı Enfeksiyonunun Teşhisi |

doktorarandevu.com : Türkiye'nin En İyi Danışmanlık ve Sağlık Hizmetlerinde Güvenilir,
Lider Platformu
Sağlık her birey için en değerli varlıktır. Fiziksel ve estetik sağlık konularında uzman
desteği almak, hayat kalitemizi artırmak ve sağlıklı bir yaşam sürmek için
oldukça önemlidir. doktorarandevu.com olarak, Ankara'nın en iyi fizyoterapistlerini
ve sağlık hizmetlerini bir araya getirerek, kullanıcılarımıza en kaliteli hizmeti sunmayı
hedefliyoruz.
Ankara En İyi Fizyoterapistler: Sağlığınızı önemsiyor ve en iyi fizyoterapistlerle
çalışmak istiyorsanız, doğru yerdesiniz. Ankara'nın en tecrübeli ve uzman
fizyoterapistlerini sizin için bir araya getiriyoruz. Uzmanlarımızın tavsiyeleriyle hareket
kabiliyetinizi artırabilir, ağrılardan kurtulabilir ve yaşam kalitenizi yükseltebilirsiniz.
Manuel Terapi ve Fizyoterapi Merkezleri: Fizik tedavi alanında birçok yöntem
bulunmaktadır, ancak manuel terapi, tedavide etkili sonuçlar elde edilen yöntemlerden
biridir. Ankara'daki fizyoterapi merkezlerinin yanı sıra manuel terapi uzmanlarıyla da
çalışma imkanı sunuyoruz. Fizik tedavi konusunda uzman doktorlarımızla sizlere en uygun
tedavi yöntemlerini sunuyoruz.
Antalya'da Burun Estetiği Doktorları: Estetik cerrahi alanında özellikle burun estetiği,
bireylerin dış görünüşünde önemli bir rol oynar. Antalya'da en iyi
burun estetiği doktorlarını sizin için bir araya getiriyor ve size doğru seçimi
yapmanızda yardımcı oluyoruz. Estetik ve sağlık konularında güvenilir ve deneyimli doktorlarla
çalışmak isterseniz, doktorarandevu.com size yardımcı olacaktır.
Ankara'da Kadın Hastalıkları ve Doğum Uzmanları: Kadın sağlığı, her kadın için
büyük önem taşır. Ankara'da en iyi kadın hastalıkları ve doğum doktorları ile
çalışmak isteyenler için doktorarandevu.com olarak, güvenilir ve deneyimli
doktorları sizlerle buluşturuyoruz. Doğru uzmanla çalışarak sağlığınızı korumanıza ve doğru
tedavi yöntemlerini bulmanıza yardımcı oluyoruz.
Online Pedagog ve Kidolog Hizmetleri: Çocukların sağlıklı ve dengeli gelişimi, pedagog ve
kidolog desteğiyle desteklenir. Online pedagog ve kidolog tavsiyeleri sunarak, çocukların
eğitim ve gelişim süreçlerinde ailelere ve çocuklara yardımcı oluyoruz. Online
danışmanlık hizmetlerimizle sizin için en uygun uzmanı bulmanızı sağlıyoruz.
Uzman Fizik Tedavi ve Kemik Tümörü Doktorları: Kemik tümörleri ve fizik
tedavi konusunda doğru uzmanlarla çalışmak, tedavi sürecini olumlu yönde etkiler.
Uzman fizik tedavi doktorları ve kemik tümörü cerrahları ile çalışma imkanı
sunuyor ve size en doğru tedaviyi belirlemenizde yardımcı oluyoruz.
Günümüzde, psikolojik sorunlar ve sağlık konularında uzman desteği almak, bireylerin
yaşam kalitesini artırmak ve problemleri çözüme kavuşturmak için
oldukça önemlidir. doktorarandevu.com olarak, psikolog siteleri ve online psikologlar
gibi alanlarda kullanıcılarımıza en iyi hizmeti sunmayı hedefliyoruz.
Psikolojik Danışmanlık Online: Hayatın getirdiği zorluklarla başa çıkmak, duygusal dengeyi
sağlamak ve daha mutlu bir yaşam sürmek için psikolojik danışmanlık online hizmetimizle
yanınızdayız. Güvenilir ve uzman psikologlarımızla çevrimiçi terapi imkanı
sunarak, sizin için en uygun çözümleri bir araya getiriyoruz.
Aile Terapisi Online: Aile içi ilişkilerde yaşanan sorunlar, her bireyi etkileyebilir.
doktorarandevu.com olarak, online aile terapisi hizmetiyle ailelerin birlikte daha sağlıklı iletişim
kurmasını ve uyumlu bir yaşam sürmesini destekliyoruz.
Evlilik ve Çift Terapisi: Evlilik çift terapisi, ilişkide yaşanan sorunların
çözümü için etkili bir yöntemdir. Uzman terapistlerimizle evlilik
ve çift terapisi alanında destek sağlayarak, ilişkinizi güçlendirmenize yardımcı
oluyoruz.
Ankara'da Fizyoterapist ve Diğer Sağlık Hizmetleri: Sağlık alanında sunduğumuz hizmetler arasında
Ankara'da fizyoterapist arayışınızı sonlandırmak için çaba gösteriyoruz. Evde
fizyoterapist hizmetinden, SGK anlaşmalı aile terapisine kadar birçok konuda sizlere yardımcı
oluyoruz.
Gebze Psikolog Yorumları ve Klinikleri: Gebze'de psikolog arayışınıza son veriyoruz.
Gebze'nin en iyi psikolog kliniklerini bir araya getirerek, sizlere doğru tercihi yapmanızda
yardımcı oluyoruz.
Manuel Terapi Seans Ücretleri ve Zararları: Manuel terapi, kas-iskelet sistemi sorunlarını
tedavi etmek için tercih edilen bir yöntemdir. Seans ücretleri ve potansiyel
zararları hakkında bilgi almak için uzmanlarımızdan destek alabilirsiniz.
Antalya Burun Estetiği Yorumları: Estetik cerrahi konusunda doğru seçimi yapmak için
Antalya'daki burun estetiği doktorlarının yorumlarını inceleyebilirsiniz. Size en uygun
seçeneği belirlemek için yardımcı oluyoruz.
Online Psikolog Tavsiye Kadınlar Kulübü: Kadınlar Kulübü kullanıcılarına
özel, güvenilir ve etkili online psikolog tavsiyeleri sunuyoruz. Sizin için en iyi
terapisti bulmanızda yardımcı oluyoruz.
Dil ve Konuşma Terapisi Sertifikası ve Eğitimi: Dil ve konuşma terapisi alanında uzmanlaşmak
isteyenlere meb onaylı sertifika eğitimi veriyoruz. Alanında uzman eğitmenlerle uzaktan eğitim
imkanı sunuyoruz.
En İyi Çift ve Aile Terapisti: Aile içi ilişkilerdeki sorunları çözmek ve
ilişkileri güçlendirmek için en iyi çift ve aile terapistlerini sizin
için bir araya getiriyoruz. Güvenilir uzmanlarla çalışmanızı sağlıyoruz.
doktorarandevu.com olarak, psikolojik danışmanlık, aile terapisi, fizyoterapi, estetik cerrahi ve
daha birçok alanda sizlere en kaliteli hizmeti sunmak için özveriyle
çalışıyoruz. Uzman kadromuz ve geniş sağlık ağımızla, ihtiyaçlarınıza uygun
çözümler üretmekteyiz. Sağlığınız ve mutluluğunuz bizim için
önemlidir.
Web sitemiz aracılığıyla uzman doktorlarımızla randevu alarak sağlığınızı koruyabilir ve yaşam
kalitenizi artırabilirsiniz. Size en uygun sağlık uzmanını kolayca bulmanız için sitemizi
ziyaret etmenizi bekliyoruz. Sağlıklı bir geleceğe adım atmak için sadece bir tık
uzaktasınız. Sağlık sizin için en değerli varlık, biz de size en iyi hizmeti sunmak
için buradayız. Sağlık ve mutluluk sizinle olsun.